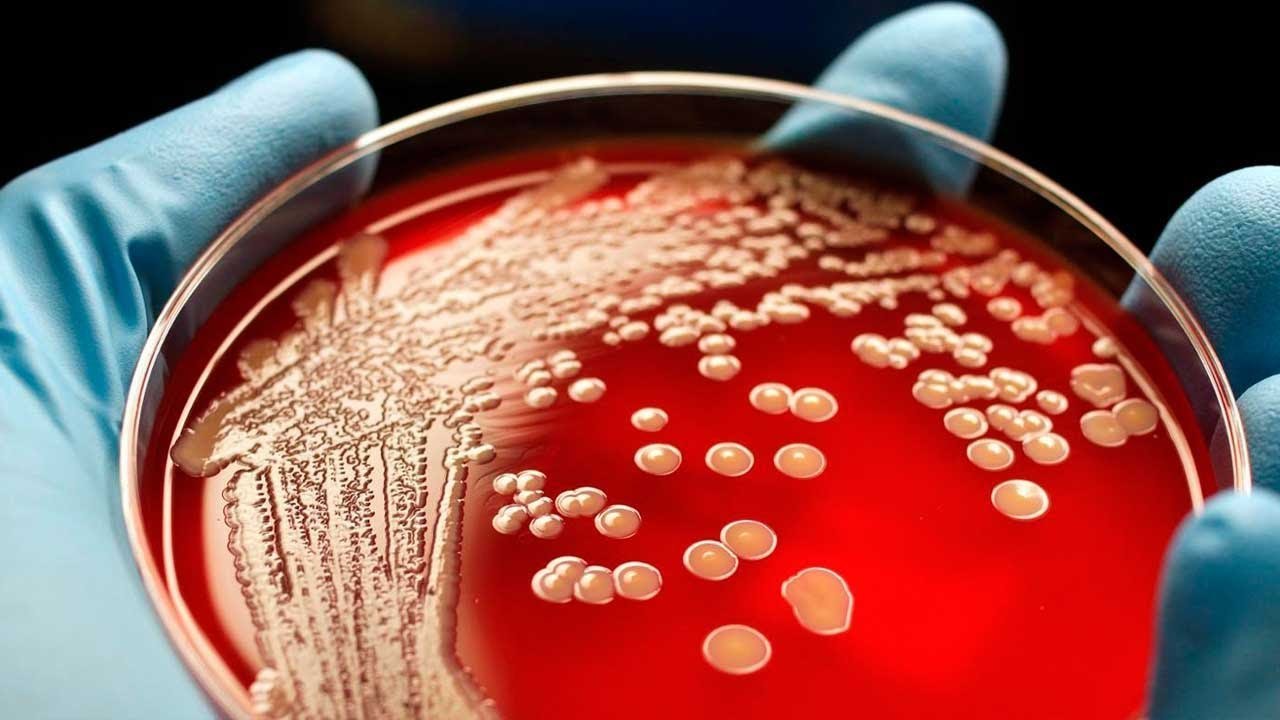

Цефепим Видео

💣 👉🏻👉🏻👉🏻 ИНФОРМАЦИЯ ДОСТУПНА ЗДЕСЬ! КЛИКАЙ 👈🏻👈🏻👈🏻
Уколы Цефепим: Инструкция по применению - YouTube
Цефепим — инструкция по применению | Medum .ru
Как разводить Цефтриаксон Лидокаином 2 % - YouTube
Цефепим - инструкция по применению, цена на Цефепим и аналоги - Likar .info
Цефепим при коронавирусе: отзывы, инструкция и действие
Цефепим - инструкция, применение, аналоги препарата, состав, показания . . .
Цефепим: для чего назначают, дозировка, аналоги
Цефепим — аналоги, цена, инструкция по применению
Клексан, цефепим, СИЗ и другие медикаменты на 2 000 000 сомов от CapstroyKG
ЦЕФЕПИМ отзывы врачей отрицательные и реальные, развод или правда, цена в аптеке . . .
Габапентин Отзывы Больных Невропатической Болью Цена
Скин Кап Для Головы
Ортофен Мазь Цена Отзывы
В данном видео представлена инструкция по применению антибактериального препарата . . .
Цефепим (Cefepime) инструкция — применение, состав, . . . (фото и видео) и инструкции могут отличаться от опубликованных и могут зависеть от производителя, упаковки, . . .
Как правильно развести антибиотик Цефтриаксон Лидокаином 2 % и стерильной водой . Разводить Новокаином или . . .
Цефепим предназначен для внутривенного или внутримышечного введения . Взрослым пациентам обычно назначается введение 1 г препарата каждые 12 часов на протяжении 7-10 дней . Для лечения тяжёлых и угрожающих жизни заболеваний доза препарата может быть увеличена до 2 г каждые 8-12 часов .
6 Видео Зачем Цефепим при коронавирусе Обнаружение только вирусного респираторного заболевания не считается основанием для применения антибиотика, поскольку такой патологический процесс не устраняется противомикробными медикаментами .
Цефепим - состав и форма выпуска препарата . Действующее вещество:сefepime; 1 флакон содержит цефепима гидрохлорида 1,2 г, эквивалентно цефепима 1,0 г; Вспомогательное вещество: L-аргинин .
Узнайте, порошок Цефепим - когда принимают, правильный способ приема, дозировка во всех . . .
Цефотаксим - рецептурный аналог Цефепима отечественного производства, который прописывается взрослым и детям с 2,5 лет . Относится к цефалоспориновому антибиотику третьего поколения широкого спектра действия . Препарат предназначен для парентерального введения . Обладает бактерицидным действием .
Клексан, цефепим, СИЗ и другие медикаменты на 2 000 000 сомов от CapstroyKG . 3540 . 23 июля 2020 10:58 . Все самое интересное в Telegram . . . . (видео) С прилавков Бишкека сметают бумагу А4 .
Цефепим не нашелся в ближайших аптеках, пришлось обзванивать, но всё-таки нашла я его в аптеке в шаговой доступности . На курс лечения купила 20 флаконов . . . . Видео обзор . Все(5) . . .
Ксарелто Цена В Таганроге 10 Мг
Антибиотик Флемоксин Солютаб Для Детей Цена
Ибуклин Юниор Отзывы Форум
Экстракт Масло Расторопши
Имунофан При Бессоннице
Детримакс Помогает
Воспаленные Миндалины Нос
Габапентин При Эпилепсии
Триттико И Корвалол Совместимость
Полижинакс Гель Инструкция
Танацехол Цена Отзывы
Кальция Глюконат Уколы Внутримышечно Можно
Сандиммун Неорал Для Собак Отзывы
Нормакс Детям Можно
Пароксетин Форма Выпуска
Лилии И Дельфиниумы На Клумбе
Москва Аптека Ру Детралекс Цена
Финлепсин Инструкция По Применению Отзывы
Энтерол Цена В Красноярске
Циклоферон Профилактика Отзывы
Коронавир Таблетки 200
Меркуриус Детям
Джес Влияние На Либидо Отзывы
Аптека Ру Синупрет В Таблетках Цена
Пилокарпин Омск
Пиаскледин 300 Цена В Аптеках Н Новгорода
Фромилид 125 Суспензия
Лактожиналь Цена В Белорецк
Дюфастон При Планировании
Цистон При Воспалении Мочевого
Здравсити Войти В Личный
Ярина Без Перерыва
Куда Делся Простопин
Дротаверин При Поносе Можно
Кларитромицин 500 При Тонзиллите
Эльбона Или Алфлутоп Что Лучше
Фемибион Содержит Железо
Климен Отзывы Женщин Принимавших Препарат
Окситоцин 10ед Инструкция
Синупрет При Гайморите Цена
Эналаприл И Каптоприл Совместимость
Аналоги Гликлазида Мв 60
Лучшие Таблетки Магний В6
Чем Отличается Глюкофаж От Метформина
Лоперамид Применение Цена
Эспиро Соник
Пироксикам Таблетки Фото
Пиридоксин Отзывы Уколы
Норваск 5 Мг Фото
Превенар Прививка Детям До Года
Улькавис Аналог Денола
Чем Растворить Даларгин
Боровая Матка Дюфастон
Ротокан Как Полоскать Десны
Колофорт Вальберис
Гепатромбин Замена
Нооклерин Инструкция Отзывы
Изофра По Аптекам Ярославль
Неотрависил Пастилки Цена
Лактаза Симптомы
Метронидазол На Ранних Сроках
Аспирин Кардиомагнил Тромбоасс
Сумамед 125мг Инструкция
Назначение Таблеток Ко Перинева
Компливит Адванс Цена
Цефазолин 2 0
Цетиризин Тева
Заболевание Миндалин Глотки Осложнение
Лизобакт Под Язык Или Нет
Тиберал Инструкция По Применению Отзывы
Гидрокарбонат Натрия Прокипятили
Сиофор 1000 Цена В Нижнем Новгороде
Ксефокам 4 Мл
Кеппра Выпадают Волосы
Мочегонные Средства При Отеках Фуросемид
Ингарон Для Профилактики
Препарат Валемидин Показания К Применению
Неогален Официальный Сайт
Таблетки Торасемид От Чего Принимают
Сколько Стоит Крем Тербинафин
Назонекс При Зависимости От Сосудосуживающих Капель
Климадинон Таблетки Аналоги
Метипред Истра
Пролиа Отзывы Пациентов Побочные
Дарунавир Отзывы
Гексорал Табс С Лидокаином
Драже Ундевит Рассасывать Или Глотать
Магний Цитрат При Беременности Отзывы
Элькар Суспензия Инструкция По Применению Цена
Ибупрофен Омск
Мукосат Уколы Цена В Красноярске
Профлосин От Чего Помогает Капсулы
Гутталакс Жевательный
Ксарелто Лекарство Цена
Мемантин 20 Мг Отзывы
Слабилен При Сильном Запоре
Индапамид Мв
Глюкозамин Хондроитин Таблетки Покрытые Оболочкой N60
Суматриптан Планета Здоровья
Какую Аллергическую Дает Кортексин
Цефепим Видео